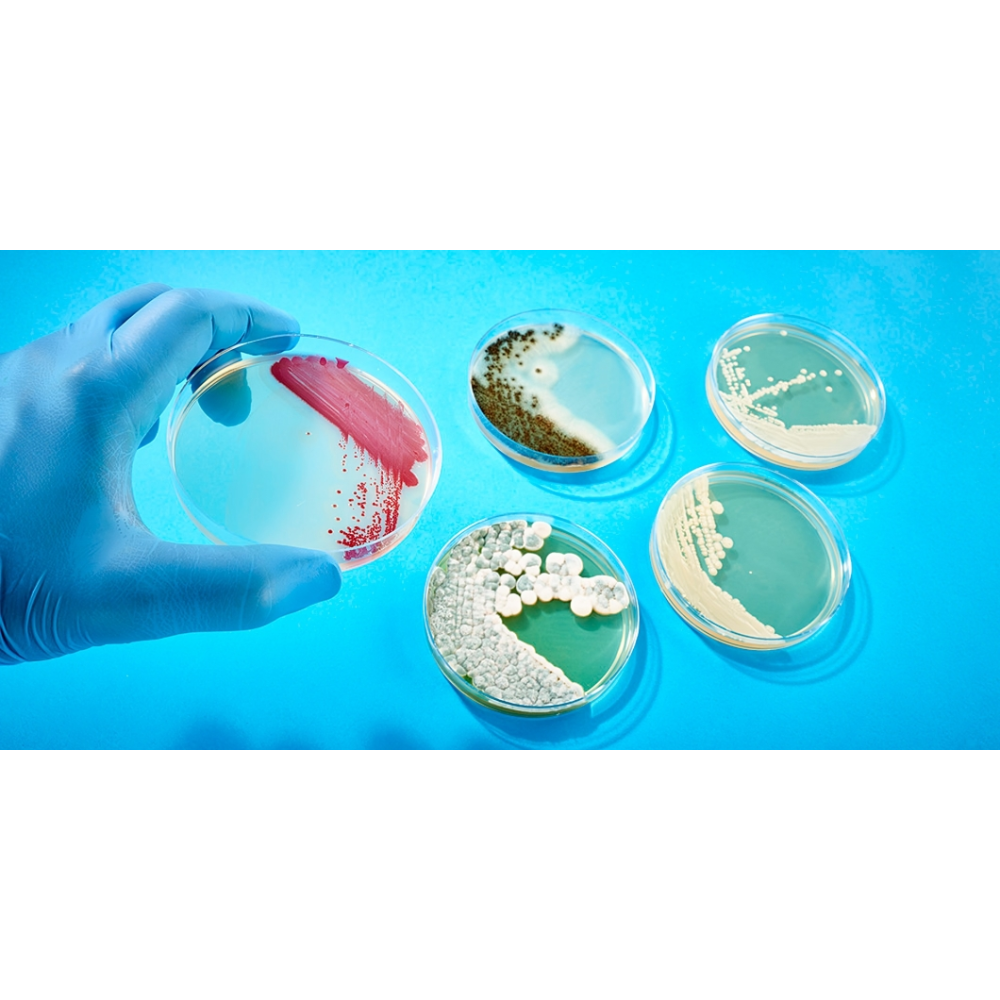

روش صحیح کار با میکروارگانیسمها
مقدمه
میکروارگانیسمها، موجودات زندهای بسیار کوچک هستند که بدون ابزار میکروسکوپی قابل مشاهده نیستند، اما نقش آنها در زندگی انسان، محیط زیست، صنایع و سلامت عمومی غیرقابل انکار است. این موجودات، از باکتریها و قارچها گرفته تا ویروسها، جلبکها و پروتوزوا، در تمامی اکوسیستمها حضور دارند و عملکردهای زیستی بسیار متنوعی را ایفا میکنند. آنها میتوانند هم مفید باشند و هم به عنوان عامل بیماریزا یا آلودهکننده عمل کنند. از این رو، شناخت دقیق این موجودات و روشهای صحیح کار با آنها یکی از پایههای اساسی در علوم زیستی، مهندسی زیستفناوری، پزشکی، کشاورزی و صنایع غذایی محسوب میشود.
اهمیت میکروارگانیسمها در حفظ سلامت انسان و محیط زیست، یکی از دلایل اصلی توجه گسترده به این حوزه است. میکروارگانیسمها نه تنها در تولید داروها، واکسنها و محصولات پروبیوتیک نقش دارند، بلکه در فرآیندهای بیورمدیشن، تصفیه فاضلاب، تولید سوختهای زیستی و بهبود کیفیت خاک و محصولات کشاورزی نیز مؤثر هستند. به عنوان مثال، برخی باکتریها و قارچها میتوانند عناصر معدنی مانند فسفر و نیتروژن را به شکل قابل جذب برای گیاه تبدیل کنند و به این ترتیب به رشد سالم گیاهان و تولید پایدار محصولات کشاورزی کمک کنند. همچنین میکروارگانیسمهای موجود در سیستم گوارشی انسان و حیوانات، نقش کلیدی در هضم غذا، تنظیم سیستم ایمنی و جلوگیری از رشد میکروبهای بیماریزا دارند.
با این حال، همانطور که میکروارگانیسمها میتوانند مفید باشند، میتوانند خطراتی نیز ایجاد کنند. برخی گونهها به عنوان عوامل بیماریزا شناخته میشوند و میتوانند موجب عفونتهای شدید، آسیب به محصولات غذایی و یا اختلال در فرآیندهای صنعتی شوند. از این رو، ایمنی زیستی و رعایت استانداردهای دقیق در کار با میکروارگانیسمها اهمیت ویژهای دارد. استانداردهای ایمنی زیستی نه تنها به محافظت از کارکنان آزمایشگاه کمک میکنند، بلکه از انتشار ناخواسته موجودات زنده و آلودگی محیط جلوگیری میکنند.
در دهههای اخیر، پیشرفتهای علمی و تکنولوژیکی، روشهای شناسایی و مدیریت میکروارگانیسمها را متحول کرده است. استفاده از روشهای مولکولی مانند PCR، توالییابی ژنومی، فناوریهای مبتنی بر نانوذرات و حسگرهای زیستی، امکان تشخیص سریع و دقیق میکروارگانیسمها را فراهم کرده است. این فناوریها به همراه استانداردهای عملیاتی دقیق، امکان کار با میکروارگانیسمها در سطح صنعتی، کشاورزی و پزشکی را با ریسک کمتر و بهرهوری بالاتر فراهم کردهاند.
هدف این مقاله، ارائه یک مرور جامع و عملی بر روی روشهای صحیح کار با میکروارگانیسمها است. در این مقاله تلاش شده است که تمامی جنبهها از شناخت و دستهبندی میکروارگانیسمها، ایمنی زیستی، روشهای شناسایی، کاربردهای صنعتی و کشاورزی، تا چالشها و راهکارهای نوین بررسی شود. مخاطب این مقاله میتواند از متخصصان آزمایشگاهی و محققان گرفته تا دانشجویان و علاقهمندان به علوم زیستی و محیط زیست باشد.
در نهایت، این مقاله قصد دارد تا دانش تخصصی و کاربردی را در یک قالب منسجم و قابل دسترس ارائه دهد و خواننده را قادر سازد تا نه تنها میکروارگانیسمها را بهتر درک کند، بلکه بتواند در محیطهای آزمایشگاهی و صنعتی با رعایت ایمنی و استانداردهای علمی، کارایی و امنیت خود و محیط را تضمین کند. رعایت این اصول، پایهای برای توسعه تحقیقات نوین، تولید محصولات باکیفیت و حفظ سلامت عمومی به شمار میرود.
شناخت میکروارگانیسمها
میکروارگانیسمها به عنوان کوچکترین موجودات زنده، در تمام محیطهای طبیعی و مصنوعی حضور دارند و تنوع بسیار گستردهای از نظر ساختاری، زیستی و عملکردی دارند. این موجودات، با وجود اندازه کوچک خود، نقشهای بزرگی در فرآیندهای زیستی، چرخههای اکولوژیک و حتی سلامت انسان ایفا میکنند. شناخت دقیق میکروارگانیسمها، اولین گام برای هر متخصصی است که قصد دارد به طور ایمن و مؤثر با این موجودات کار کند.
دستهبندی میکروارگانیسمها
میکروارگانیسمها بر اساس ویژگیهای ساختاری و زیستی به چند گروه اصلی تقسیم میشوند که هر گروه ویژگیها و کاربردهای خاص خود را دارد:
-
باکتریها: این گروه یکی از قدیمیترین و متنوعترین میکروارگانیسمهاست. باکتریها تکسلولی هستند و فاقد هسته مشخص میباشند، اما دارای دیواره سلولی و ساختارهای درونسلولی ساده هستند. برخی باکتریها مفیدند و در فرآیندهایی مانند هضم غذا، تولید دارو و کودهای زیستی نقش دارند، در حالی که برخی دیگر عامل بیماریهای انسانی، حیوانی و گیاهی هستند. باکتریها بر اساس شکل و ساختار دیواره سلولی خود به گرم مثبت و گرم منفی تقسیمبندی میشوند که این ویژگی در شناسایی و انتخاب روشهای درمانی و ایمنی اهمیت دارد.
-
قارچها: قارچها میتوانند تکسلولی مانند مخمرها یا چندسلولی مانند کپکها باشند. آنها نقش مهمی در تجزیه مواد آلی و تولید ترکیبات صنعتی مانند آنتیبیوتیکها و آنزیمها ایفا میکنند. با این حال، برخی قارچها نیز میتوانند عامل عفونتهای انسانی یا آلودگی محصولات غذایی باشند، بنابراین شناخت آنها و روشهای ایمن کار با آنها ضروری است.
-
ویروسها: ویروسها موجوداتی غیرسلولی هستند که تنها در داخل سلولهای میزبان قادر به تکثیر هستند. آنها میتوانند حیوانات، گیاهان و حتی باکتریها را آلوده کنند. ویروسها از نظر اندازه، ساختار ژنتیکی و شیوه انتقال تنوع دارند. با توجه به توانایی بالقوه آنها در ایجاد بیماریهای شدید، رعایت استانداردهای ایمنی زیستی در کار با ویروسها اهمیت فوقالعادهای دارد.
-
جلبکها و سیانوباکتریها: این گروه از میکروارگانیسمها قادر به فتوسنتز هستند و نقش مهمی در تولید اکسیژن، چرخه کربن و تغذیه موجودات دیگر دارند. آنها در صنایع غذایی، تولید بیوفیلمها و برخی فرآیندهای محیطزیستی نیز کاربرد دارند.
-
پروتوزوا و سایر تکیاختهایها: این گروه شامل موجوداتی تکسلولی با ساختارهای پیچیدهتر است و برخی از آنها میتوانند عامل بیماریهای انسانی و حیوانی باشند. پروتوزواها معمولاً در محیطهای آبی و خاکی یافت میشوند و نقش مهمی در شبکههای غذایی و چرخههای اکولوژیک دارند.
نقش میکروارگانیسمها در اکوسیستم و زندگی انسان
میکروارگانیسمها نه تنها به عنوان موجودات مستقل اهمیت دارند، بلکه نقشهایشان در شبکههای زیستی و تعامل با دیگر موجودات، پایهای برای اکوسیستمهای پایدار است. آنها در تجزیه مواد آلی، تثبیت نیتروژن، تولید ترکیبات زیستی و حتی کنترل جمعیت سایر موجودات نقش دارند. به عنوان مثال، باکتریهای تثبیتکننده نیتروژن، بخشی از نیتروژن جو را به شکل قابل استفاده برای گیاهان تبدیل میکنند، در حالی که قارچهای میکوریزا با ایجاد ارتباط با ریشه گیاهان، جذب مواد معدنی و آب را بهبود میبخشند.
در حوزه انسانی، میکروارگانیسمها میتوانند هم مفید باشند و هم مضر. میکروارگانیسمهای مفید، مانند پروبیوتیکها، با ایجاد تعادل میکروبی در روده، به هضم غذا و تقویت سیستم ایمنی کمک میکنند. در مقابل، میکروارگانیسمهای بیماریزا میتوانند باعث عفونتهای شدید، مسمومیت غذایی و مشکلات بهداشتی شوند. از این رو، شناخت دقیق گونهها و رفتار آنها، از ضروریات اولیه برای هر متخصصی است که قصد دارد به طور ایمن و مؤثر با این موجودات کار کند.
میکروارگانیسمهای مفید و مضر: تمایز و تشخیص
یکی از چالشهای مهم در کار با میکروارگانیسمها، تمایز میان گونههای مفید و مضر است. این تمایز نه تنها بر انتخاب روشهای ایمنی تأثیر میگذارد، بلکه در کاربردهای صنعتی و تحقیقاتی نیز اهمیت دارد. میکروارگانیسمهای مفید، علاوه بر نقش تغذیهای و زیستی، در صنایع دارویی، غذایی و محیطزیستی نیز کاربرد دارند. به عنوان مثال، استفاده از باکتریهای فسفاتسولوبیلایزر میتواند رشد گیاهان را افزایش دهد و نیاز به کودهای شیمیایی را کاهش دهد، در حالی که گونههای مضر ممکن است باعث آلودگی محصولات غذایی یا انتشار بیماری شوند.
برای تشخیص و تمایز این گونهها، متخصصان از ابزارهای متعدد استفاده میکنند، از جمله روشهای سنتی مانند کشت و میکروسکوپی و روشهای مولکولی و نوین مانند PCR، توالییابی ژنومی و حسگرهای زیستی. این ابزارها امکان شناسایی دقیق گونهها و حتی زیرگونهها را فراهم میکنند و پایهای برای تصمیمگیریهای ایمنی و کاربردی محسوب میشوند.
ایمنی زیستی و استانداردهای کار با میکروارگانیسمها
کار با میکروارگانیسمها، به ویژه گونههای بیماریزا یا صنعتی، مستلزم رعایت دقیق اصول ایمنی زیستی و استانداردهای علمی است. ایمنی زیستی مجموعهای از اقدامات، پروتکلها و تجهیزات حفاظتی است که با هدف محافظت از کارکنان، محیط آزمایشگاه و جامعه در برابر خطرات ناشی از میکروارگانیسمها به کار گرفته میشود. رعایت این اصول نه تنها سلامت فردی را تضمین میکند، بلکه از انتشار تصادفی میکروبهای خطرناک جلوگیری میکند و باعث افزایش کیفیت و دقت تحقیقات میشود.
سطوح ایمنی زیستی و طبقهبندی میکروارگانیسمها
میکروارگانیسمها بر اساس میزان خطر و قابلیت انتقالشان به انسان، حیوان یا محیط، به چهار سطح ایمنی زیستی (Biosafety Levels: BSL-1 تا BSL-4) تقسیم میشوند:
-
سطح ایمنی زیستی یک (BSL-1) :این سطح برای میکروارگانیسمهای شناخته شده و کمخطر که معمولاً بیماریزا نیستند، مناسب است. در این سطح، اقدامات ایمنی پایه مانند شستشوی دستها، استفاده از روپوش آزمایشگاهی و رعایت اصول کار تمیز کافی است. این سطح معمولاً در آموزشگاهها و آزمایشگاههای آموزشی به کار میرود.
-
سطح ایمنی زیستی دو (BSL-2) :این سطح برای میکروارگانیسمهایی که ممکن است باعث بیماری شوند ولی درمان آنها در دسترس است، تعریف میشود. در این سطح، علاوه بر تجهیزات ایمنی پایه، استفاده از دستکش، محافظ چشم، هود لامینار و پروتکلهای محدودکننده انتشار هوا الزامی است. نمونههایی مانند باکتریهای پاتوژن انسانی مانند E. coli بیماریزا یا ویروسهای ضعیفشده، در این سطح بررسی میشوند.
-
سطح ایمنی زیستی سه (BSL-3) :این سطح برای میکروارگانیسمهای خطرناک که از طریق هوا منتقل میشوند و میتوانند بیماری جدی ایجاد کنند، کاربرد دارد. در این سطح، آزمایشگاهها دارای سیستمهای تهویه خاص، دسترسی محدود و تجهیزات حفاظتی کامل هستند. نمونهها باید در کابینتهای بیولوژیکی ویژه بررسی شوند و کارکنان آموزشهای ویژه دیده باشند.
-
سطح ایمنی زیستی چهار (BSL-4) :این سطح برای میکروارگانیسمهای بسیار خطرناک و بدون درمان مؤثر یا واکسن تعریف میشود، مانند ویروس ابولا و ماربورگ. در این سطح، تمام اقدامات حفاظتی حداکثری اعمال میشود، شامل لباسهای فشار مثبت، سیستمهای ورود و خروج کنترلشده و فضای ایزوله.
تجهیزات حفاظتی فردی (PPE) و استانداردهای محیطی
یکی از اصلیترین ابزارهای ایمنی زیستی، استفاده صحیح از تجهیزات حفاظتی فردی است. این تجهیزات شامل روپوشهای آزمایشگاهی مقاوم در برابر نفوذ، دستکشهای یکبار مصرف، ماسک یا محافظ تنفسی، عینک ایمنی و در برخی موارد لباسهای فشار مثبت هستند. تجهیزات حفاظتی نه تنها کارکنان را از تماس مستقیم با میکروارگانیسمها محافظت میکنند، بلکه از انتقال میکروب به محیط آزمایشگاه و جامعه جلوگیری میکنند.
علاوه بر تجهیزات فردی، استانداردهای محیطی نیز اهمیت بالایی دارند. آزمایشگاهها باید دارای تهویه مناسب، سیستمهای فیلتراسیون هوا، ضدعفونی منظم سطوح، مدیریت صحیح زبالههای زیستی و پروتکلهای ورود و خروج کارکنان باشند. رعایت دقیق این استانداردها، به ویژه در سطوح BSL-2 تا BSL-4، از انتشار میکروارگانیسمها به محیطهای خارج از آزمایشگاه جلوگیری میکند.
نگهداری، انتقال و دفع میکروارگانیسمها
یکی دیگر از جنبههای مهم ایمنی زیستی، مدیریت نمونهها و میکروارگانیسمها است. نمونههای زیستی باید در ظروف مقاوم و قابل مهر و موم نگهداری شوند و در طول انتقال به آزمایشگاهها، شرایط دمایی و فشار مناسب حفظ شود. انتقال نمونهها باید تحت پروتکلهای مشخص و توسط افراد آموزشدیده انجام شود تا از هرگونه آلودگی یا انتشار جلوگیری شود.
پس از پایان کار، دفع صحیح میکروارگانیسمها اهمیت ویژهای دارد. این کار معمولاً با استفاده از اتوکلاو کردن، ضدعفونی شیمیایی و یا فرآیندهای خاص دیگر انجام میشود تا میکروارگانیسمها غیر فعال شوند و هیچ خطری برای کارکنان یا محیط ایجاد نکنند.
اقدامات پیشگیرانه و آموزش کارکنان
هیچ سیستمی بدون آموزش مؤثر کارکنان کامل نیست. آموزش مستمر کارکنان آزمایشگاه در زمینه اصول ایمنی زیستی، شناسایی خطرات، روشهای مقابله با حوادث و پروتکلهای اضطراری، از ارکان کلیدی ایمنی محسوب میشود. این آموزشها باید شامل تمرینهای عملی، ارزیابی دانش و بروزرسانی مداوم پروتکلها باشند.
استانداردهای بینالمللی و ملی
در سطح جهانی، سازمانهایی مانند سازمان جهانی بهداشت (WHO)، مراکز کنترل و پیشگیری از بیماریها (CDC) و سازمان غذا و دارو (FDA) استانداردهای مشخصی برای کار با میکروارگانیسمها ارائه میدهند. این استانداردها، شامل دستهبندی میکروارگانیسمها، تجهیزات حفاظتی، پروتکلهای ضدعفونی و مدیریت زبالههای زیستی هستند و به آزمایشگاهها کمک میکنند تا کار خود را مطابق با بهترین شیوههای بینالمللی انجام دهند.
در مجموع، رعایت اصول ایمنی زیستی و استانداردهای علمی، پایه و اساس کار مؤثر با میکروارگانیسمها است. این اصول به متخصصان امکان میدهند که بدون به خطر انداختن سلامت خود یا دیگران، تحقیقات و کاربردهای صنعتی و پزشکی خود را با دقت و کارایی بالا انجام دهند.
روشهای شناسایی و تشخیص میکروارگانیسمها
شناسایی میکروارگانیسمها یکی از ارکان اصلی کار تخصصی در علوم زیستی، پزشکی، کشاورزی و صنایع مرتبط با میکروارگانیسمها محسوب میشود. به دلیل تنوع بسیار بالای میکروارگانیسمها و تفاوتهای عملکردی آنها، روشهای متنوعی برای شناسایی و تشخیص آنها توسعه یافته است. این روشها را میتوان به سه دسته کلی تقسیم کرد: روشهای سنتی، روشهای مولکولی و روشهای نوین و هوشمند.
روشهای سنتی شناسایی میکروارگانیسمها
روشهای سنتی شناسایی میکروارگانیسمها بر پایه مشاهده مستقیم یا غیرمستقیم خصوصیات فیزیکی، مورفولوژیک و زیستی آنها استوار است. این روشها، گرچه به نظر ابتدایی میآیند، همچنان در بسیاری از آزمایشگاهها کاربرد دارند و پایهای برای درک رفتار و ویژگیهای میکروارگانیسمها فراهم میکنند.
یکی از روشهای رایج، کشت میکروبی است. در این روش، نمونهها در محیطهای کشت اختصاصی قرار میگیرند تا رشد میکروارگانیسمها تسهیل شود. نوع محیط کشت، دما، رطوبت و میزان اکسیژن، نقش مهمی در انتخاب و رشد گونههای خاص دارند. با بررسی کلونیها از نظر شکل، رنگ، اندازه و الگوهای رشد، میتوان اطلاعات مهمی درباره گونههای موجود به دست آورد.
روش دیگر، رنگآمیزی میکروسکوپی است. رنگآمیزی گرم، یکی از پرکاربردترین روشها برای تمایز باکتریهای گرم مثبت و گرم منفی است و اطلاعات مهمی درباره ساختار دیواره سلولی فراهم میکند. سایر روشهای رنگآمیزی شامل رنگآمیزی متیلم بلو، فاز کنتراست و فلورسانس است که برای شناسایی قارچها، پروتوزوا و برخی باکتریها استفاده میشوند.
روشهای مولکولی شناسایی میکروارگانیسمها
با پیشرفت علم زیستفناوری، روشهای مولکولی برای شناسایی میکروارگانیسمها توسعه یافتهاند که دقت، سرعت و قابلیت تشخیص گونههای غیرقابل کشت را افزایش میدهند. PCR یا واکنش زنجیرهای پلیمراز یکی از برجستهترین روشهاست که امکان تکثیر و شناسایی دقیق ژنهای خاص میکروارگانیسمها را فراهم میکند. این روش به ویژه در شناسایی باکتریها و ویروسهای پاتوژن، تشخیص سریع بیماریها و کنترل اپیدمیها بسیار مفید است.
توالییابی ژنومی و متاژنومیک نیز روشهای قدرتمندی برای تحلیل ترکیب میکروبی محیطها، از خاک و آب گرفته تا نمونههای انسانی، فراهم میکنند. این روشها میتوانند گونهها و حتی زیرگونهها را شناسایی کنند و اطلاعات دقیقی درباره مقاومت دارویی، ژنهای تولید متابولیت و شبکههای تعامل میکروبی ارائه دهند.
روشهای نوین و هوشمند شناسایی میکروارگانیسمها
در دهههای اخیر، استفاده از فناوریهای نوین، شناسایی میکروارگانیسمها را سریعتر و دقیقتر کرده است. حسگرهای زیستی و نانوذرات نمونهای از این فناوریها هستند که امکان تشخیص سریع میکروبها در نمونههای پیچیده را فراهم میکنند. این روشها به ویژه در صنایع غذایی، پزشکی و محیط زیست کاربرد دارند، جایی که سرعت و دقت شناسایی اهمیت حیاتی دارد.
پوششها و مواد ضدباکتری هوشمند نیز ابزارهای جدیدی هستند که میتوانند با تغییر رنگ یا تولید سیگنالهای قابل مشاهده، وجود میکروارگانیسمها را نشان دهند. این فناوریها در محیطهای صنعتی و بیمارستانی، به منظور پیشگیری از آلودگی و مدیریت ریسک، اهمیت فراوانی دارند.
تفاوتها و مزایای روشهای مختلف
هر روش شناسایی مزایا و محدودیتهای خود را دارد. روشهای سنتی، ارزان و در دسترس هستند اما زمانبر بوده و برای گونههای غیرقابل کشت محدودیت دارند. روشهای مولکولی دقت و سرعت بالایی دارند اما نیازمند تجهیزات تخصصی و هزینه بالاتر هستند. روشهای نوین و هوشمند، سریع و دقیق هستند و میتوانند در محیطهای واقعی و صنعتی مورد استفاده قرار گیرند، اما هنوز در برخی موارد نیاز به تأیید و توسعه بیشتر دارند.
اهمیت شناسایی دقیق میکروارگانیسمها
تشخیص دقیق میکروارگانیسمها نه تنها برای پژوهشهای علمی و صنعتی اهمیت دارد، بلکه در حفظ ایمنی زیستی، پیشگیری از بیماریها و مدیریت فرآیندهای محیطی نیز نقش حیاتی ایفا میکند. به عنوان مثال، شناسایی سریع باکتریهای مقاوم به آنتیبیوتیک در بیمارستانها، امکان اتخاذ تصمیمات درمانی سریع و کاهش ریسک اپیدمیها را فراهم میکند. در صنایع غذایی، شناسایی به موقع میکروبهای آلودهکننده، از فساد محصول جلوگیری کرده و سلامت مصرفکنندگان را تضمین میکند.
اصول کار آزمایشگاهی با میکروارگانیسمها
کار در آزمایشگاه میکروبیولوژی مستلزم رعایت اصولی است که هم سلامت کارکنان را تضمین میکند و هم کیفیت و دقت نتایج را حفظ میکند. این اصول شامل آمادهسازی محیط کشت، تکنیکهای استریل، نمونهبرداری، انتقال و نگهداری طولانیمدت میکروارگانیسمها است. رعایت دقیق این نکات، پایهای برای تمامی تحقیقات و کاربردهای صنعتی و پزشکی محسوب میشود.
آمادهسازی محیط کشت و شرایط رشد میکروارگانیسمها
یکی از مراحل اولیه و اساسی، آمادهسازی محیط کشت مناسب است. محیط کشت باید متناسب با نوع میکروارگانیسم انتخاب شود، زیرا هر گونه نیازهای تغذیهای، دمایی و شرایط محیطی خاص خود را دارد. به عنوان مثال، برخی باکتریها و قارچها نیازمند محیطهای غنی از مواد آلی و رطوبت بالا هستند، در حالی که برخی میکروارگانیسمهای خاکزی یا فتوسنتزی به شرایط خاصی از نور و pH نیاز دارند.
دمای مناسب، میزان رطوبت و سطح اکسیژن، نقش مهمی در موفقیت رشد میکروارگانیسمها دارند. در بسیاری از آزمایشگاهها، انکوباتورها و دستگاههای کنترل دما و رطوبت برای ایجاد شرایط ایدهآل استفاده میشوند. همچنین، محیط کشت باید از نظر pH و ترکیبات یونی تنظیم شود تا رشد سالم و قابل پیشبینی میکروبها تضمین شود.
تکنیکهای استریل و جلوگیری از آلودگی متقاطع
یکی از چالشهای اصلی در کار آزمایشگاهی، جلوگیری از آلودگی متقاطع است. آلودگی میتواند منجر به نتایج نادرست، هدر رفت منابع و حتی خطرات زیستی شود. استفاده از هود لامینار، اتوکلاو کردن وسایل و محیطهای کشت، ضدعفونی سطوح و دستها، از مهمترین اقدامات برای جلوگیری از آلودگی است.
ابزارها و تجهیزات باید قبل و بعد از استفاده استریل شوند و نمونهها به دقت مدیریت شوند. به عنوان مثال، پیپتها، لولهها و پلیتهای کشت باید یا یکبار مصرف باشند یا با روشهای اتوکلاو یا حرارت خشک، ضدعفونی شوند. همچنین، کار با میکروارگانیسمها باید به گونهای انجام شود که تماس مستقیم با دست، پوست یا سطوح آلوده کاهش یابد.
نمونهبرداری و انتقال میکروارگانیسمها
نمونهبرداری صحیح، بخش کلیدی در کار آزمایشگاهی است. هر گونه اشتباه در این مرحله میتواند باعث آلودگی، از بین رفتن نمونه یا تشخیص نادرست شود. نمونهها باید با استفاده از وسایل استریل جمعآوری شوند و در ظروف مقاوم و مهر و موم شده نگهداری شوند.
انتقال نمونهها نیز باید تحت شرایط کنترل شده انجام شود. حفظ دما، رطوبت و فشار مناسب در طول انتقال، به ویژه برای میکروارگانیسمهای حساس، حیاتی است. در بسیاری از آزمایشگاهها، از جعبههای حمل مخصوص با پوشش ضدعفونی و علامتهای هشدار دهنده استفاده میشود تا از هر گونه تماس تصادفی یا نشت نمونه جلوگیری شود.
نگهداری طولانیمدت و ذخیرهسازی میکروارگانیسمها
برای تحقیقات بلندمدت، میکروارگانیسمها باید به شیوهای ذخیره شوند که ساختار و عملکرد آنها حفظ شود. روشهای مختلفی برای این کار وجود دارد، از جمله فریز کردن در دمای بسیار پایین، خشک کردن با اسپری یا استفاده از محیطهای محافظتکننده با گلیسرول و سایر کربوهیدراتها. انتخاب روش مناسب بسته به نوع میکروارگانیسم، مدت زمان ذخیرهسازی و اهداف تحقیق تعیین میشود.
مدیریت ایمنی در محیط آزمایشگاهی
همزمان با رعایت تکنیکهای عملی، ایمنی شخصی و محیطی باید همواره در اولویت باشد. کارکنان باید از لباسهای محافظ، دستکش، ماسک و عینک ایمنی استفاده کنند و از خوردن، نوشیدن یا لمس کردن صورت در آزمایشگاه خودداری کنند. مدیریت زبالههای زیستی، شامل پسماندهای کشت شده، ابزارهای آلوده و محیطهای کاری، نیز باید مطابق پروتکلهای ایمنی انجام شود تا هیچ میکروارگانیسم زندهای به محیط بیرون منتقل نشود.
اهمیت آموزش و پایبندی به پروتکلها
هیچ مجموعهای از تجهیزات یا استانداردها به تنهایی کافی نیست؛ آموزش مستمر کارکنان و پایبندی دقیق به پروتکلها، عامل اصلی موفقیت در کار آزمایشگاهی است. کارکنان باید قادر باشند خطرات بالقوه را شناسایی کنند، اقدامات پیشگیرانه را به درستی اجرا کنند و در صورت بروز حادثه، واکنش مناسب داشته باشند.
کاربرد میکروارگانیسمها در صنایع مختلف
میکروارگانیسمها با وجود اندازه بسیار کوچک خود، در بسیاری از صنایع نقش حیاتی دارند و میتوانند به تولید محصولات با ارزش، حفظ محیط زیست و بهبود سلامت انسان کمک کنند. استفاده از میکروارگانیسمها در صنایع مختلف، نتیجه شناخت دقیق آنها، کنترل ایمنی زیستی و بهرهگیری از روشهای نوین شناسایی و تشخیص است. کاربردهای میکروارگانیسمها را میتوان به چند حوزه اصلی تقسیم کرد: صنایع غذایی، دارویی، کشاورزی، محیط زیست و انرژی.
صنایع غذایی
در صنایع غذایی، میکروارگانیسمها نقشهای متعددی دارند و هم به عنوان عامل تولید و هم عامل کنترل کیفیت به کار گرفته میشوند. پروبیوتیکها، که شامل باکتریهای مفید مانند Lactobacillus و Bifidobacterium هستند، در تولید محصولات لبنی و مکملهای غذایی به منظور ارتقای سلامت روده و تقویت سیستم ایمنی کاربرد دارند. همچنین، میکروارگانیسمها در تولید مواد تخمیری مانند ماست، پنیر، کیمچی و نان نقش اساسی دارند. در این فرآیندها، باکتریها و مخمرها با متابولیتهای خود طعم، بافت و ارزش تغذیهای محصول را بهبود میبخشند.
علاوه بر این، میکروارگانیسمها در کنترل کیفیت و ایمنی مواد غذایی اهمیت دارند. استفاده از باکتریهای مفید به عنوان بیوکنتل یا استفاده از پوششهای ضدباکتری هوشمند، میتواند از رشد میکروارگانیسمهای بیماریزا جلوگیری کند و عمر مفید محصولات را افزایش دهد. فناوریهای نوین مانند حسگرهای زیستی و تشخیص سریع میکروبها در خط تولید مواد غذایی، به پیشگیری از آلودگی و کاهش ریسک سلامت مصرفکننده کمک میکنند.
صنایع دارویی و بیوتکنولوژی
میکروارگانیسمها در صنایع دارویی، به ویژه در تولید آنتیبیوتیکها، آنزیمها، واکسنها و داروهای بیولوژیکی کاربرد دارند. باکتریها و قارچها قادر به تولید ترکیبات متابولیتی با فعالیت ضدباکتری و ضدقارچی هستند که به عنوان دارو یا مکملهای درمانی مورد استفاده قرار میگیرند. برای مثال، تولید پنیسیلین توسط قارچ Penicillium و تولید استرپتومایسین توسط باکتریهای جنس Streptomyces نمونههای بارزی از کاربرد میکروارگانیسمها در داروسازی هستند.
همچنین، میکروارگانیسمها در توسعه داروهای نوین و درمانهای شخصیسازی شده نقش دارند. آنها به عنوان میزبانهای بیولوژیکی برای بیان پروتئینهای دارویی، آنزیمها و واکسنها مورد استفاده قرار میگیرند. روشهای نوین مانند بیوانفورماتیک، مهندسی ژنتیک و متاژنومیک، امکان شناسایی و بهینهسازی گونههای میکروبی را برای تولید ترکیبات ارزشمند دارویی فراهم میکنند.
صنایع کشاورزی و بیوفرتیلایزرها
میکروارگانیسمها نقش کلیدی در تغذیه گیاهان و بهبود کیفیت خاک دارند. استفاده از باکتریهای فسفاتسولوبیلایزر، تثبیتکننده نیتروژن و تولیدکننده هورمونهای رشد، باعث افزایش بهرهوری کشاورزی و کاهش وابستگی به کودهای شیمیایی میشود. همچنین، قارچهای میکوریزا با ایجاد ارتباط متقابل با ریشه گیاهان، جذب مواد مغذی و آب را بهبود میبخشند و گیاهان را در برابر تنشهای محیطی مانند شوری، خشکی یا اسیدیته مقاوم میسازند.
بیوکنتلها و کنترل زیستی آفات نیز نمونه دیگری از کاربرد میکروارگانیسمها در کشاورزی هستند. باکتریها و قارچهای مفید میتوانند جمعیت آفات و عوامل بیماریزا را کنترل کنند، بدون آن که نیاز به سموم شیمیایی مضر باشد. این امر به کشاورزی پایدار و حفظ محیط زیست کمک میکند.
صنایع محیط زیست و بیورمدیشن
میکروارگانیسمها در پاکسازی محیط زیست و بیورمدیشن کاربرد گسترده دارند. باکتریها، قارچها و جلبکها قادر به تجزیه ترکیبات آلی، نفت و فلزات سنگین هستند و میتوانند آلایندهها را به محصولات غیرمضر تبدیل کنند. این فرآیندها در تصفیه فاضلاب صنعتی، بازیابی خاکهای آلوده و کاهش اثرات زیستمحیطی صنایع کاربرد دارند.
برای مثال، باکتریهای نفتخوار در بازیابی مخازن نفتی و کاهش رسوبات خطرناک مؤثرند، و قارچها با تولید آنزیمهای خاص میتوانند ترکیبات پیچیده آلی را تجزیه کنند. استفاده از میکروارگانیسمها در محیط زیست، رویکردی پایدار و اقتصادی برای مقابله با آلودگیها ارائه میدهد و با کاهش نیاز به روشهای شیمیایی، اثرات جانبی منفی را به حداقل میرساند.
صنایع انرژی و بیوپروسسها
میکروارگانیسمها در تولید انرژیهای تجدیدپذیر و بیوگازها نیز نقش دارند. باکتریها و جلبکها قادر به تولید متان، هیدروژن و بیودیزل از مواد آلی و پسماندهای صنعتی هستند. این فرآیندها به عنوان جایگزینی پایدار برای سوختهای فسیلی عمل میکنند و نقش مهمی در کاهش انتشار گازهای گلخانهای و حفظ محیط زیست دارند.
استفاده از میکروارگانیسمهای الکتروفعال در سلولهای سوختی میتواند تولید انرژی الکتریکی را از مواد زیستی ممکن سازد، که به توسعه فناوریهای انرژی پاک و نوآورانه کمک میکند.
خلاصه اهمیت کاربرد میکروارگانیسمها در صنایع
به طور کلی، میکروارگانیسمها با قابلیتهای بینظیر خود، صنایع مختلف را متحول کردهاند. آنها نه تنها تولید محصولات با ارزش را ممکن میسازند، بلکه به حفظ محیط زیست، ارتقای سلامت انسان و کشاورزی پایدار کمک میکنند. ترکیب دانش دقیق میکروبیولوژی، ایمنی زیستی و روشهای نوین شناسایی، امکان بهرهبرداری حداکثری از این موجودات کوچک ولی قدرتمند را فراهم میآورد.
چالشها و ریسکها در کار با میکروارگانیسمها
کار با میکروارگانیسمها، گرچه فرصتهای بیشماری برای پیشرفت علمی، صنعتی و پزشکی ایجاد میکند، اما همزمان با چالشها و ریسکهای بالقوهای همراه است که میتواند سلامت کارکنان، ایمنی محیط آزمایشگاه و حتی جامعه را تهدید کند. شناخت دقیق این ریسکها و اتخاذ اقدامات پیشگیرانه، بخش جداییناپذیر کار علمی حرفهای است.
خطرات زیستی و بیماریزا
یکی از اصلیترین ریسکها، احتمال انتقال میکروارگانیسمهای بیماریزا به انسان یا حیوان است. برخی باکتریها، ویروسها و قارچها میتوانند باعث بیماریهای شدید یا حتی تهدیدکننده زندگی شوند. نمونههایی مانند Salmonella, Mycobacterium tuberculosis, ویروسهای آنفولانزا یا ابولا نشان میدهند که یک اشتباه کوچک در مدیریت نمونهها یا رعایت نکردن پروتکلهای ایمنی میتواند پیامدهای جدی به همراه داشته باشد.
برای کاهش این ریسک، استفاده از سطوح ایمنی زیستی مناسب، تجهیزات حفاظتی شخصی و آموزش دقیق کارکنان ضروری است. حتی در آزمایشگاههای با سطح ایمنی بالا، پروتکلهای اضطراری و اقدامات سریع برای مدیریت نشت نمونهها باید وجود داشته باشد.
آلودگی متقاطع و خطای آزمایشگاهی
آلودگی متقاطع یکی دیگر از چالشهای مهم است. در صورتی که نمونهها با یکدیگر تماس پیدا کنند یا ابزارهای آزمایشگاهی به درستی استریل نشوند، نتایج آزمایشها نادرست خواهند بود. این موضوع میتواند منجر به تصمیمگیریهای غلط در زمینه تشخیص بیماری، تولید صنعتی یا تحقیقات علمی شود.
پیشگیری از آلودگی متقاطع شامل استفاده از تکنیکهای استریل، مدیریت صحیح نمونهها، جداسازی محیطها و نظارت مداوم بر تجهیزات است. آموزش مداوم کارکنان و رعایت دقیق پروتکلها، نقش مهمی در کاهش این خطر دارد.
مقاومت میکروبی و ریسکهای زیستمحیطی
رشد میکروارگانیسمهای مقاوم به دارو و آنتیبیوتیک، یکی دیگر از ریسکهای جدی در محیط آزمایشگاه و صنایع است. این میکروبها نه تنها درمان بیماریها را دشوار میکنند، بلکه در صورت انتشار به محیط زیست، میتوانند چرخههای اکولوژیکی و سلامت انسان و حیوان را تحت تأثیر قرار دهند.
برای مدیریت این ریسک، استفاده از میکروارگانیسمهای کنترلشده، نظارت بر محیط آزمایشگاه و جلوگیری از رهاسازی نمونهها به محیط، حیاتی است. همچنین، پژوهشهای مداوم برای شناسایی ژنهای مقاومت و استفاده از روشهای ایمن برای مهندسی ژنتیک میکروبها، به کاهش خطر کمک میکند.
چالشهای مدیریتی و فنی
مدیریت آزمایشگاههای میکروبیولوژی، به ویژه در محیطهای صنعتی و پژوهشی پیشرفته، با چالشهای فنی و مدیریتی همراه است. این چالشها شامل نگهداری صحیح تجهیزات، تأمین محیطهای کشت استاندارد، مدیریت زبالههای زیستی و حفظ شرایط ایمنی پایدار میشوند. هرگونه کوتاهی در مدیریت این جنبهها میتواند به کاهش کیفیت تحقیقات، هدر رفت منابع و افزایش ریسک زیستی منجر شود.
ریسکهای روانی و انسانی
کار با میکروارگانیسمهای خطرناک، علاوه بر خطرات فیزیکی، میتواند استرس و اضطراب را برای کارکنان ایجاد کند. نگرانی از آلودگی، بیماری یا خطاهای احتمالی، نیازمند آموزش روانی، برنامههای ایمنی و حمایت سازمانی است. ایجاد فرهنگ ایمنی و حمایت از کارکنان، از عوامل کلیدی در کاهش ریسکهای انسانی است.
چالشهای قانونی و اخلاقی
استفاده از میکروارگانیسمها در تحقیق و صنعت با مسائل قانونی و اخلاقی همراه است. قوانینی درباره رهاسازی میکروبها، استفاده از ژنهای مهندسی شده، تولید داروها و مواد غذایی، و حفاظت از محیط زیست وجود دارد. رعایت دقیق این قوانین، نه تنها از پیامدهای حقوقی جلوگیری میکند، بلکه اعتماد عمومی را به تحقیقات علمی و محصولات صنعتی افزایش میدهد.
راهکارهای کاهش ریسک و مدیریت چالشها
برای کاهش ریسکها و مدیریت چالشها، اقدامات زیر توصیه میشود:
-
پیروی دقیق از سطوح ایمنی زیستی و استانداردهای بینالمللی.
-
استفاده از تجهیزات حفاظتی فردی و سیستمهای ایمنی محیطی.
-
آموزش مستمر کارکنان در زمینه شناسایی ریسکها و واکنش به حوادث.
-
مدیریت صحیح نمونهها، زبالهها و مواد آلوده.
-
پایش و نظارت مداوم بر شرایط محیطی و تجهیزات آزمایشگاهی.
-
توسعه فرهنگ ایمنی و مسئولیتپذیری در میان تمامی کارکنان.
-
رعایت قوانین، مقررات و اصول اخلاقی مرتبط با کار با میکروارگانیسمها.
راهکارهای افزایش ایمنی و کارایی در کار با میکروارگانیسمها
رعایت اصول ایمنی و افزایش کارایی در کار با میکروارگانیسمها، نه تنها سلامت کارکنان و محیط را تضمین میکند، بلکه کیفیت و دقت نتایج علمی و صنعتی را به شدت بهبود میبخشد. راهکارهای مؤثر برای دستیابی به این اهداف، شامل اقدامات پیشگیرانه، تکنولوژیهای نوین، آموزش و مدیریت حرفهای است.
استفاده از تجهیزات و فناوریهای پیشرفته
یکی از مهمترین راهکارها، بهرهگیری از تجهیزات آزمایشگاهی مدرن و فناوریهای پیشرفته است. هودهای لامینار، اتوکلاوها، انکوباتورها و دستگاههای کنترل دما و رطوبت، محیطی ایمن و مناسب برای رشد و نگهداری میکروارگانیسمها فراهم میکنند. همچنین، استفاده از سنسورها و سیستمهای مانیتورینگ آنلاین، شرایط محیطی و رشد میکروبها را به صورت لحظهای پایش میکند و امکان پیشگیری از آلودگی و خطاهای آزمایشگاهی را فراهم میسازد.
استفاده از مواد و محیطهای کشت ایمن و بهینه
انتخاب محیط کشت مناسب و ایمن، یکی از عوامل کلیدی افزایش کارایی است. محیطهای کشت باید از نظر ترکیبات غذایی، pH، میزان رطوبت و اکسیژن، نیازهای گونههای مورد نظر را بهینه کنند. استفاده از محیطهای کشت از پیش استریل شده و استاندارد، خطر آلودگی و خطا در نتایج را کاهش میدهد. همچنین، افزودن مواد محافظ مانند گلیسرول یا کربوهیدراتها میتواند برای نگهداری طولانیمدت میکروارگانیسمها مفید باشد.
پیروی از پروتکلهای ایمنی و استانداردهای بینالمللی
رعایت دقیق پروتکلهای ایمنی زیستی و استانداردهای جهانی، پایهای برای کاهش ریسکها و افزایش کارایی است. سطوح ایمنی زیستی (BSL-1 تا BSL-4) بسته به نوع میکروارگانیسمها و خطرات بالقوه تعیین میشوند. کارکنان باید با تمام دستورالعملها آشنا باشند و پروتکلهای استریل، انتقال نمونه، مدیریت زباله و واکنش به حادثه را رعایت کنند.
آموزش مستمر و فرهنگ ایمنی
آموزش مداوم کارکنان، یکی از مؤثرترین راهکارها برای افزایش ایمنی و کارایی است. کارکنان باید خطرات بالقوه، تکنیکهای صحیح نمونهبرداری، انتقال و کشت میکروبها، و استفاده صحیح از تجهیزات حفاظتی را بدانند. ایجاد فرهنگ ایمنی، جایی که هر عضو تیم مسئولیتپذیر باشد و ایمنی را در اولویت قرار دهد، باعث کاهش حوادث و بهبود کیفیت کار میشود.
مدیریت ریسک و برنامههای اضطراری
شناسایی و مدیریت ریسکها، بخش جداییناپذیر افزایش ایمنی است. آزمایشگاهها باید ارزیابی ریسک جامع برای تمام فعالیتها، تعیین نقاط بحرانی و ایجاد برنامههای اضطراری داشته باشند. این برنامهها شامل واکنش به نشت نمونه، آلودگی محیطی یا حوادث شخصی است. تمرینات دورهای و شبیهسازی شرایط اضطراری، کارکنان را برای مواجهه با هرگونه مشکل آماده میکند.
استفاده از میکروارگانیسمهای اصلاحشده و کنترلشده
یکی دیگر از راهکارهای افزایش ایمنی، استفاده از سویههای میکروبی کنترلشده یا اصلاحشده است. این سویهها اغلب فاقد ژنهای بیماریزا هستند یا توانایی زنده ماندن در محیط بیرون از آزمایشگاه را ندارند. استفاده از چنین میکروبهایی، ریسک آلودگی و انتقال بیماری را کاهش میدهد و امکان انجام آزمایشهای پیشرفته با ایمنی بالاتر را فراهم میکند.
مدیریت صحیح نمونهها و زبالههای زیستی
راهکار دیگری که هم ایمنی و هم کارایی را افزایش میدهد، مدیریت اصولی نمونهها و زبالههای زیستی است. نمونهها باید به صورت مهر و موم شده، با برچسبهای دقیق و در شرایط کنترلشده نگهداری شوند. زبالههای زیستی نیز باید با روشهای استاندارد مانند اتوکلاو یا سوزاندن تحت شرایط کنترلشده دفع شوند. این اقدامها، از انتشار میکروارگانیسمها به محیط و آلودگی متقاطع جلوگیری میکند.
پیادهسازی فناوریهای نوین برای کنترل رشد و تشخیص سریع
استفاده از سنسورهای زیستی، نانوذرات، پوششهای ضدباکتری هوشمند و سیستمهای تشخیص سریع، کارایی و ایمنی را همزمان افزایش میدهد. این فناوریها امکان تشخیص زودهنگام آلودگی، کنترل رشد میکروبها و پیشگیری از خطرات بالقوه را فراهم میکنند.
هماهنگی میان ایمنی و بهرهوری
یکی از چالشهای کلیدی، ایجاد تعادل میان ایمنی و بهرهوری است. رعایت دقیق ایمنی نباید باعث کاهش سرعت و کیفیت کار شود و بالعکس، تلاش برای افزایش بهرهوری نباید ایمنی را به خطر بیندازد. تدوین سیاستها و استانداردهای عملیاتی که هر دو جنبه را پوشش دهند، کلید موفقیت در محیطهای پژوهشی و صنعتی است.
پیشرفتها و تحقیقات نوین در حوزه میکروارگانیسمها
در دهههای اخیر، حوزه میکروبیولوژی با تحولات چشمگیر علمی و فناوری مواجه شده است. این پیشرفتها نه تنها درک ما از میکروارگانیسمها و نقش آنها در محیط و سلامت انسان را بهبود دادهاند، بلکه امکان توسعه کاربردهای نوآورانه در صنایع، پزشکی، کشاورزی و محیط زیست را فراهم کردهاند.
تحقیقات متاژنومیک و ژنومیک
یکی از برجستهترین پیشرفتها، استفاده از متاژنومیک و ژنومیک برای شناسایی و تحلیل میکروارگانیسمهاست. این روشها امکان مطالعه مستقیم ژنومها و جامعههای میکروبی بدون نیاز به کشت سنتی را فراهم میکنند. با متاژنومیک، دانشمندان قادرند تنوع میکروبی، ژنهای عملکردی و مسیرهای متابولیکی را شناسایی کنند و گونههای ناشناختهای که در محیط طبیعی وجود دارند را کشف کنند. این پیشرفت، کاربرد میکروارگانیسمها در صنایع دارویی، بیوفرتیلایزرها و تصفیه زیستی را تسهیل کرده است.
مهندسی ژنتیک و میکروبهای اصلاحشده
پیشرفت در مهندسی ژنتیک، امکان طراحی و اصلاح میکروارگانیسمها برای تولید محصولات خاص، افزایش مقاومت به تنشها و بهبود عملکرد را فراهم کرده است. برای مثال، باکتریها و مخمرهای اصلاحشده میتوانند داروهای زیستی، آنزیمهای صنعتی، بیوپلاستیکها و سوختهای زیستی تولید کنند. استفاده از میکروبهای اصلاحشده همچنین به کاهش خطرات زیستی و افزایش کارایی فرآیندهای صنعتی کمک میکند.
بیورمدیشن و فناوریهای سبز
تحقیقات نوین در زمینه بیورمدیشن و کاربردهای محیط زیستی میکروارگانیسمها، به توسعه روشهای پایدار برای پاکسازی آلایندهها، بازیابی خاکهای آلوده و تصفیه فاضلاب منجر شده است. استفاده از میکروارگانیسمهای الکتروفعال و ترکیبی، امکان تجزیه ترکیبات پیچیده، نفت و فلزات سنگین را فراهم میآورد. فناوریهای نوین مانند نانوبیوتکنولوژی و پوششهای هوشمند میکروبی، کارایی این فرآیندها را افزایش داده و اثرات زیستمحیطی منفی را کاهش میدهند.
میکروبیوم انسان و تحقیقات پزشکی نوین
تحقیقات پیشرفته بر روی میکروبیوم انسان، بینشهای جدیدی درباره سلامت، بیماری و تعامل میکروبها با میزبان ارائه داده است. مطالعات نشان دادهاند که توازن میکروبی روده، پوست و سایر ارگانها نقش کلیدی در سیستم ایمنی، متابولیسم و حتی سلامت روان دارد. این یافتهها به توسعه پروبیوتیکها، پریبیوتیکها و درمانهای شخصیسازی شده کمک کردهاند.
همچنین، روشهای تشخیصی نوین مانند بیوسنسورها، سیستمهای پاسخ سریع و تحلیلهای ژنومیک، امکان شناسایی سریع عوامل بیماریزا را فراهم کرده و به کاهش شیوع بیماریها کمک میکنند.
اکوسیستمهای میکروبی و شبکههای تعاملی
مطالعات اخیر نشان دادهاند که میکروارگانیسمها به صورت شبکههای پیچیده با یکدیگر تعامل دارند و وابستگیهای تغذیهای و ارتباطات شیمیایی، ساختار و عملکرد جامعههای میکروبی را شکل میدهند. فهم این شبکهها، امکان طراحی اکوسیستمهای مصنوعی، کنترل بهتر رشد میکروبها و بهینهسازی فرآیندهای صنعتی را فراهم کرده است.
نانوتکنولوژی و میکروارگانیسمها
ادغام نانوتکنولوژی و میکروبیولوژی، راهکارهای نوینی برای بهبود کارایی و ایمنی ارائه داده است. استفاده از نانوذرات میکروبی، پوششهای ضدباکتری هوشمند و سیستمهای تحویل دارو، کاربرد میکروارگانیسمها را در صنایع غذایی، پزشکی و محیط زیست افزایش داده است. این فناوریها امکان کنترل دقیق رشد میکروبها و واکنشهای متابولیکی آنها را فراهم میکنند.
تحقیقات در حوزه مقاومت میکروبی و آنتیبیوتیکها
با افزایش نگرانیها در مورد مقاومت میکروبی به آنتیبیوتیکها، تحقیقات نوین به توسعه راهکارهای جایگزین و ترکیبات نوآورانه متمرکز شدهاند. استفاده از میکروبهای تولیدکننده ترکیبات ضدباکتری هوشمند، بیوکنتلها و فناوریهای سنتز داروهای جدید، از مهمترین دستاوردهای این حوزه است.
پیشرفت در فناوریهای تشخیصی و مانیتورینگ
تحقیقات نوین، به ویژه در زمینه حسگرهای زیستی، تشخیص مولکولی و فناوریهای بیوشیمیایی، امکان پایش دقیق و سریع میکروارگانیسمها را فراهم کرده است. این پیشرفتها هم در آزمایشگاهها و هم در محیطهای صنعتی و کشاورزی کاربرد دارند و به بهبود ایمنی، افزایش بهرهوری و کاهش خطاهای انسانی کمک میکنند.
جمعبندی و نتیجهگیری
کار با میکروارگانیسمها یکی از پیچیدهترین و در عین حال جذابترین حوزههای علمی و صنعتی است. در طول این مقاله، تلاش شد تا تمام جنبههای شناخت، ایمنی، کاربرد و نوآوریهای مرتبط با میکروارگانیسمها بهطور جامع مورد بررسی قرار گیرد.
شناخت میکروارگانیسمها، پایه و اساس هر فعالیتی در این حوزه است. میکروبها شامل باکتریها، ویروسها، قارچها و پروتوزوآها میشوند و نقش حیاتی در چرخههای زیستی، تولید مواد مفید، سلامت انسان و محیط زیست دارند. درک دقیق ساختار، متابولیسم و رفتار آنها، پیشنیاز طراحی هرگونه فرآیند علمی، صنعتی یا پزشکی است.
در کنار شناخت، ایمنی زیستی و رعایت استانداردها، ستون اصلی فعالیتهای موفق و پایدار با میکروارگانیسمهاست. تعیین سطح ایمنی زیستی مناسب، استفاده از تجهیزات حفاظتی و ایجاد محیطهای کنترلشده، ریسک انتقال بیماری و آلودگی متقاطع را به حداقل میرساند. همچنین، فرهنگ ایمنی و آموزش مستمر کارکنان تضمین میکند که رعایت پروتکلها به یک عادت و مسئولیت جمعی تبدیل شود.
روشهای شناسایی و تشخیص میکروارگانیسمها با پیشرفت فناوریهای مولکولی، بیوشیمیایی و نانوتکنولوژیک، سرعت، دقت و قابلیت اطمینان بالاتری پیدا کردهاند. استفاده از متاژنومیک، حسگرهای زیستی و فناوریهای پاسخ سریع، امکان پایش محیطها، نمونهها و محصولات صنعتی را به صورت دقیق و در زمان واقعی فراهم میآورد.
کاربرد میکروارگانیسمها در صنایع مختلف شامل پزشکی، کشاورزی، محیط زیست، صنایع غذایی و دارویی، به دلیل تواناییهای متنوع آنها روزبهروز گسترش یافته است. میکروبها میتوانند بیوفرتیلایزر، تصفیهکننده زیستی آلایندهها، تولیدکننده داروها و ترکیبات صنعتی و حتی عامل کنترل بیولوژیکی بیماریها باشند. این کاربردها نشان میدهند که میکروارگانیسمها نه تنها ابزار علمی، بلکه منابع ارزشمند اقتصادی و زیستمحیطی نیز هستند.
با وجود این فرصتها، چالشها و ریسکها مانند خطرات زیستی، آلودگی متقاطع، مقاومت میکروبی، مسائل قانونی و فشارهای روانی کارکنان، اهمیت مدیریت دقیق و پایبندی به پروتکلهای ایمنی را برجسته میکنند. این موضوع نشان میدهد که هر نوآوری یا کاربرد صنعتی بدون ارزیابی ریسک، آموزش و مدیریت صحیح میتواند خطرات جدی ایجاد کند.
راهکارهای افزایش ایمنی و کارایی، شامل استفاده از تجهیزات پیشرفته، محیطهای کشت بهینه، میکروارگانیسمهای کنترلشده، مدیریت نمونهها و زبالههای زیستی، و فناوریهای نوین تشخیص و پایش است. پیادهسازی این راهکارها، تضمین میکند که فعالیتهای پژوهشی و صنعتی هم ایمن و پایدار و هم با کیفیت و بهرهوری بالا باشند.
تحقیقات نوین، مانند مطالعات میکروبیوم، مهندسی ژنتیک، بیورمدیشن، نانوتکنولوژی و متاژنومیک، افقهای تازهای برای کاربرد میکروارگانیسمها باز کردهاند. این پیشرفتها نشان میدهند که حوزه میکروبیولوژی در حال تحول مستمر است و میتواند مسائل پیچیده محیط زیستی، کشاورزی، پزشکی و صنعتی را با راهکارهای نوآورانه حل کند.
در نهایت، میتوان نتیجه گرفت که کار با میکروارگانیسمها تلفیقی از علم، ایمنی و نوآوری است. موفقیت در این حوزه نیازمند شناخت دقیق میکروبها، رعایت استانداردها، بهرهگیری از فناوریهای نوین، مدیریت ریسک و ایجاد فرهنگ ایمنی و مسئولیتپذیری است. هر متخصص یا صنعتی که بتواند این عوامل را به صورت یکپارچه اجرا کند، میتواند از مزایای علمی، اقتصادی و زیستمحیطی میکروارگانیسمها بهرهمند شود و همزمان ایمنی انسان و محیط زیست را تضمین کند.
در نهایت، چشمانداز آینده کار با میکروارگانیسمها روشن است و با ادامه تحقیقات، توسعه فناوریها و افزایش آگاهی ایمنی، میتوان انتظار داشت که این حوزه به یک ستون حیاتی در علوم زندگی، صنایع پایدار و سلامت جهانی تبدیل شود.




